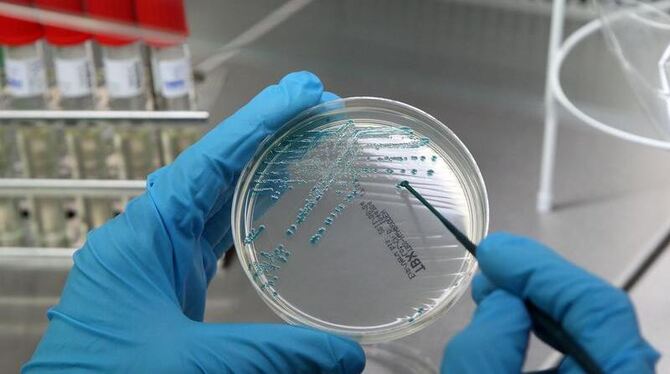

REUTLINGEN/STUTTGART. Weihnachtsüberraschung für das Naturwissenschaftliche und Medizinische Institut NMI in Reutlingen: Das Stuttgarter Wirtschaftsministerium fördert den Kauf eines neuen Laborgebäudes mit fünf Millionen Euro. Die Gesamtkosten des Neubaus betragen 7,8 Millionen Euro. Das neue Gebäude werde dem Institut neue Möglichkeiten als Forschungspartner für kleine und mittlere Unternehmen bieten, »die aufgrund des hohen Kostendrucks keine eigenen Forschungskapazitäten vorhalten können, aber dennoch ständig neuen Anforderungen gerecht werden müssen«, sagte Wirtschaftsministerin Nicole Hoffmeister-Kraut (CDU) in Stuttgart.
Bisheriges Gebäude starkt sanierungsbedürftig
Das bisherige Gebäude ist stark sanierungsbedürftig. Um die Labors darin wieder auf einen modernen Stand zu bringen, wäre ein erheblicher finanzieller Aufwand nötig. Außerdem hatten das Wachstum von rund 50 Prozent bei den Projekteinnahmen in den letzten Jahren und der personelle Zuwachs um etwa 30 Prozent das NMI auch flächenmäßig an seine Grenzen gebracht. Das alte Gebäude wird nun mit weniger Aufwand saniert und weiter genutzt.
Das Reutlinger Institut betreibt angewandte Forschung an der Schnittstelle zwischen Bio- und Materialwissenschaften und konzentriert sich auf die Entwicklung marktfähiger Produkte und Verfahren in den Bereichen Pharma und Biotechnologie, Biomedizintechnik, Oberflächen- und Grenzflächentechnologie. Die Forschungseinrichtung beschäftigt mehr als 200 Mitarbeiter. Erst vor einem Jahr hatte das NMI neue Forschungsgeräte erhalten, deren Anschaffung das Stuttgarter Ministerium mit 700 000 Euro gefördert hatte. Das NMI ist Mitglied der Innovationsallianz Baden-Württemberg, deren 13 Institute eine Brücke zwischen der Grundlagenforschung und der Entwicklung in Unternehmen bilden. (jr)